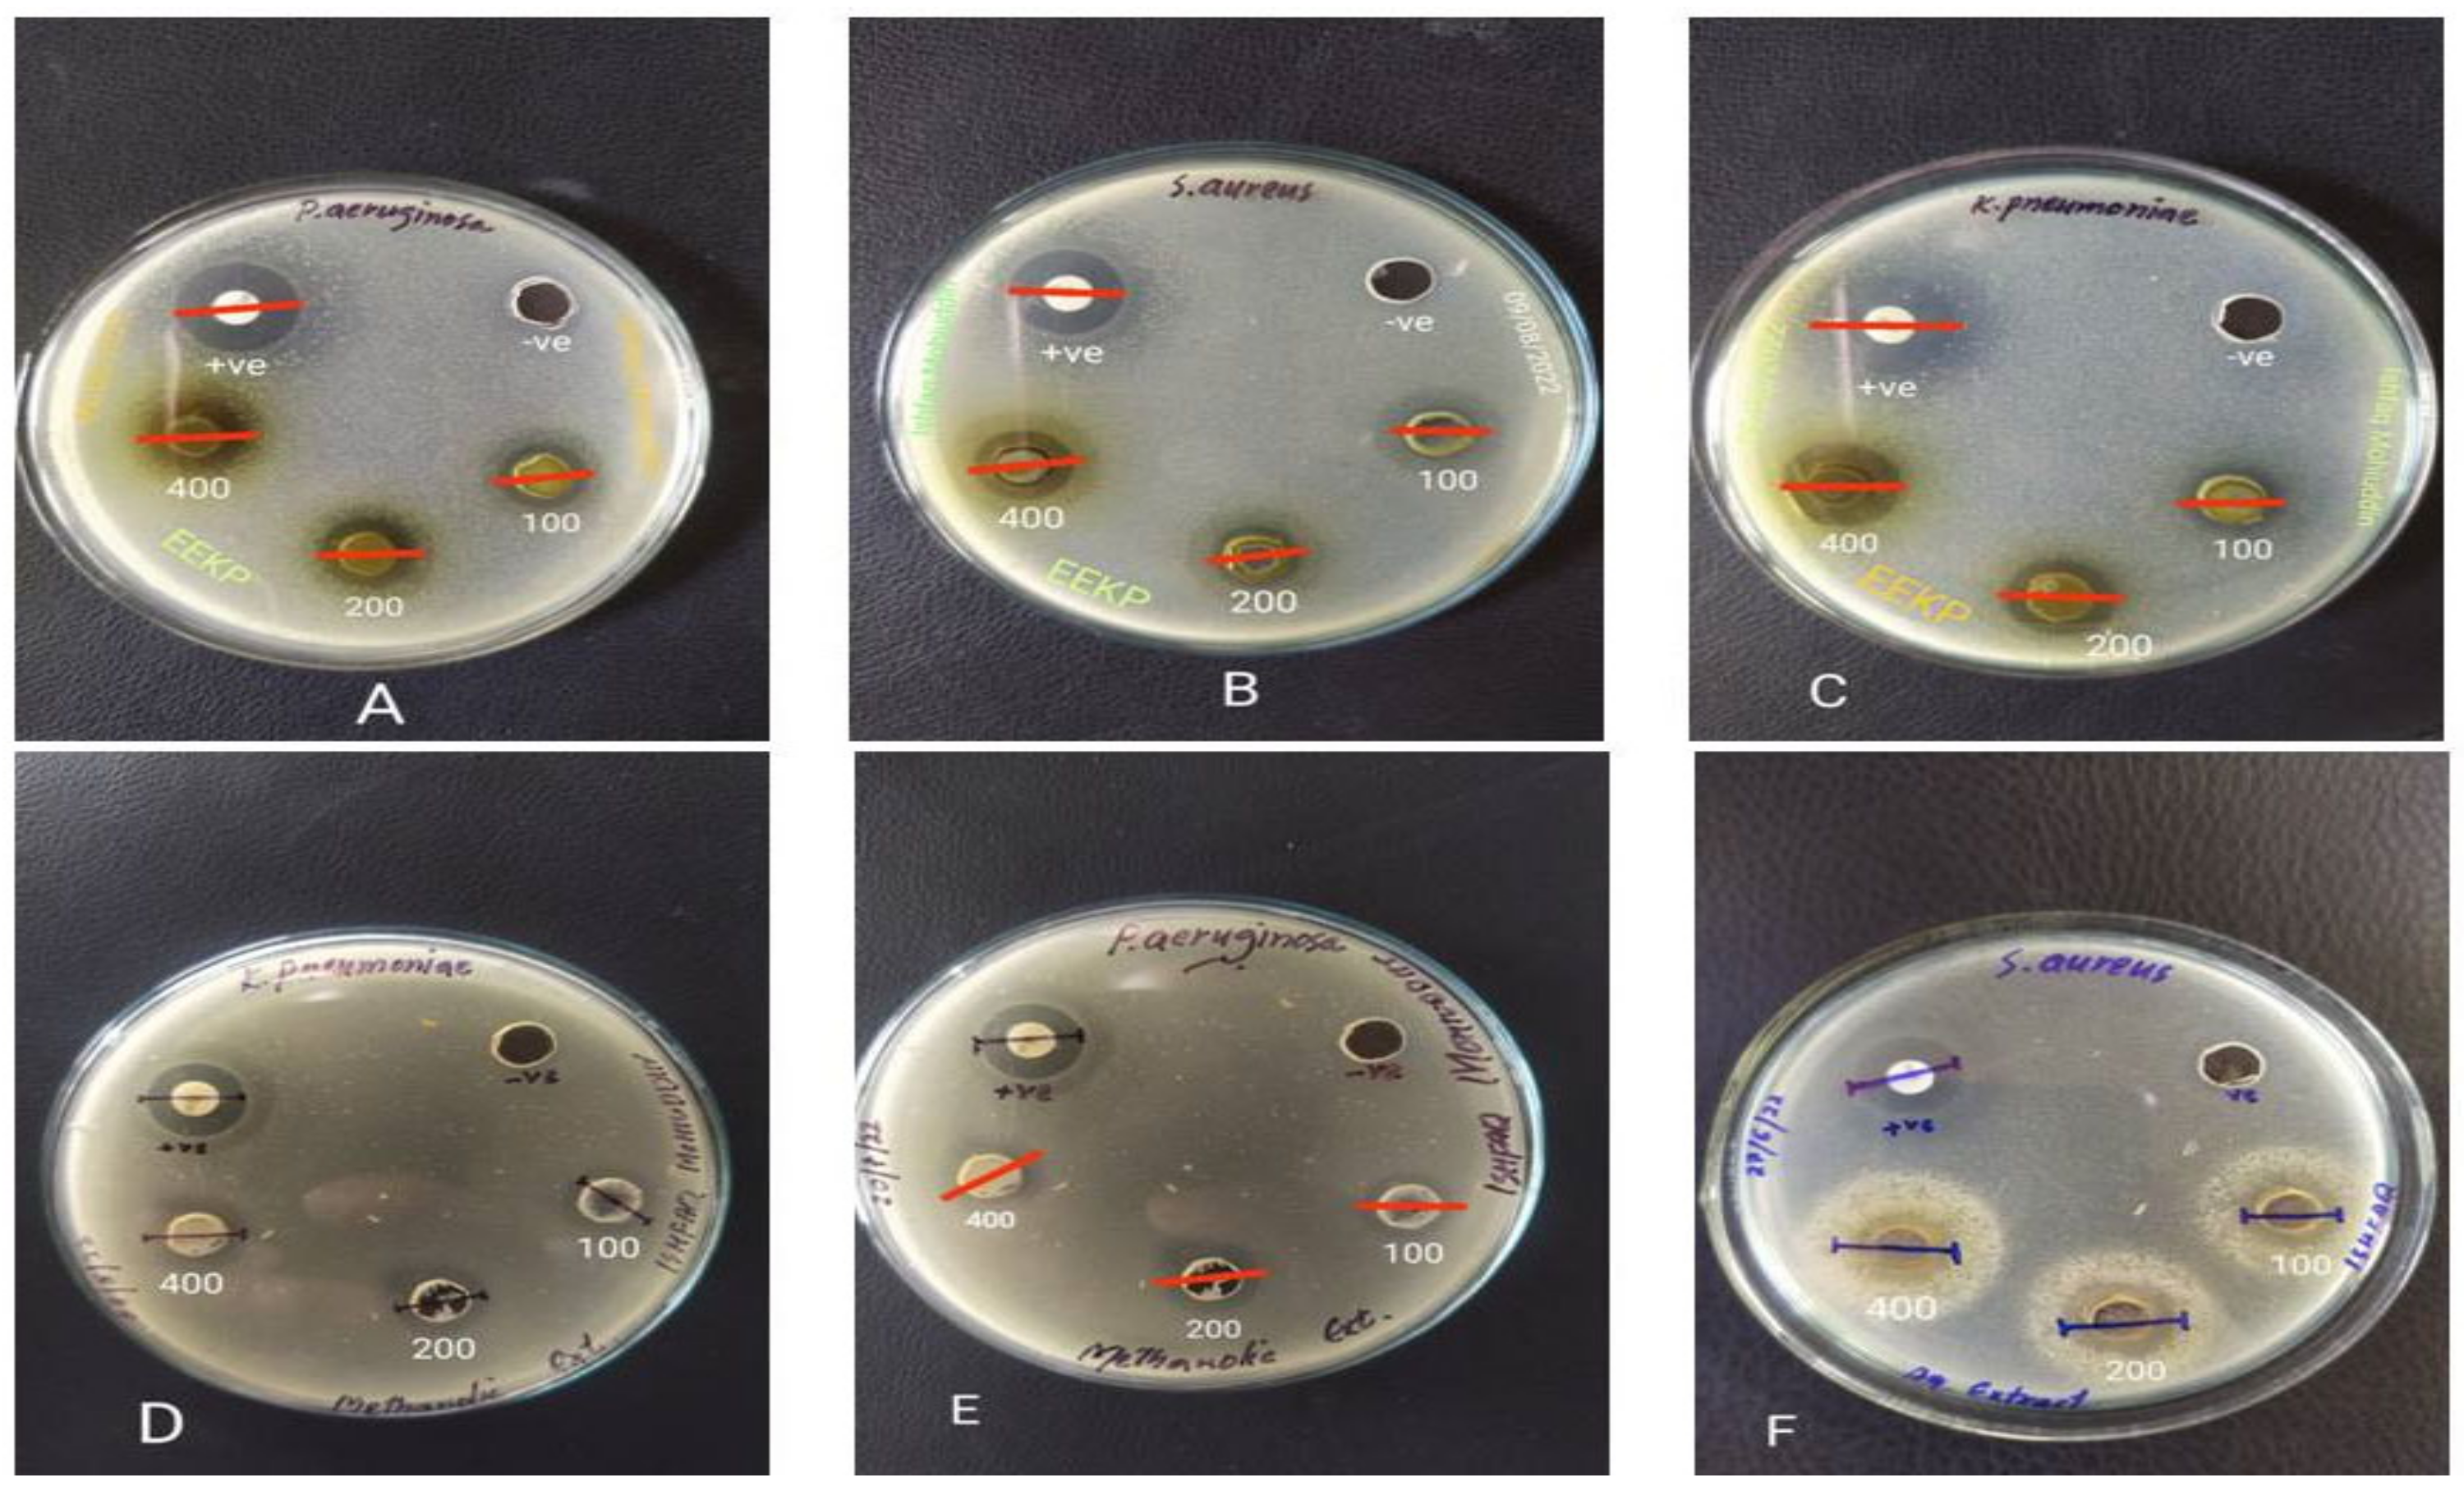
Separations 09 00363 g003

Abstract
Propolis is a resinous compound produced by honey bees. It contains bioactive molecules that possess a wide range of biological functions. The chemical composition of propolis is affected by various variables, including the vegetation, the season, and the area from which the sample was collected. The aim of this study was to analyze the chemical composition and assess Cerana indica propoli’s antibacterial efficacy from the Kashmir region. Gas chromatography-mass spectrometry (GC-MS) analysis was used to determine the chemical composition of Kashmiri propolis. A range of bacterial strains was tested for antimicrobial activity using different extracts of propolis by agar well diffusion technique. Propolis was found to be rich in alkaloids, saponins, tannins, and resins. The chemical characterization revealed the presence of 68 distinct phytocompounds using GC-MS, and the most predominant compounds were alpha-D-mannopyranoside, methyl, cyclic 2,3:4,6-bis-ethyl boronate (21.17%), followed by hexadecanoic acid, methyl ester (9.91%), and bacteriochlorophyll-c-stearyl (4.41%). The different extracts of propolis showed specific antibacterial efficacy against multidrug-resistant (MDR) strains viz., Pseudomonas aeruginosa (MTCC1688), Escherichiacoli (MTCC443), Klebsiella pneumonia (MTCC19), Cutibacterium acnes (MTCC843), and Staphylococcus aureus (MTCC96). The EEKP showed the highest zone of inhibition against S. aureus (17.33) at 400 µg mL−1. According to the findings of this study, bee propolis contains a variety of secondary metabolites with various pharmacological activities. Furthermore, because of its broad spectrum of positive pharmacological actions and the fact that it is a promising antibacterial agent, more research on propolis is warranted.
1. Introduction
Propolis (also known as bee glue) derives its name from the Greek word pro, which means “in front of” or “at the entrance to,” and polis, which means “community” or “city”. This natural substance is a unique mixture of various natural components with distinct properties and aids in the protection of the beehive [1,2]. It is made up of a resinous substance that honeybees collect from the buds and exudates of certain trees and plants, which they then combine with beeswax and the enzyme-rich secretion of bee salivary glands, including β-glycosidase [3,4,5].
Honeybee colonies frequently employ propolis for hive repairs as a sealant to plug the cracks and restrict the openings, limiting the entry of intruders and maintaining the temperature inside the hive at the ideal level for bees, about 35 °C [6]. In addition, they embalm dead invaders with bee glue to prevent decomposition, protect the bee larvae, store honey, and remove potential sources of microbial infestations [7]. Propolis becomes sticky when above room temperature, but it is hard and brittle at low temperatures [8]. It has a very distinctive and pleasant aroma. Depending on its origin and age, its coloration varies from yellow to red to dark brown. Even the existence of transparent propolis has been reported [9,10]. Propolis has been revealed to have antimicrobial properties [11,12], and it has been used for centuries in traditional medicine and remedies.
The complex chemical content of propolis is constantly changing due to various geographical conditions; generally, raw propolis is composed of plant resin (45–55%), wax (25–35%), essential (5–10%), and aromatic oils (5%), pollen, and other natural components (5%). [13]. Depending on the species of bee, the plant’s origin, the habitat, and the storage conditions, thechemical composition of propolis varies [14,15]. So far, over 300 chemical compounds have been isolated and identified from the propolis, including sugars, polyols, hydroxy acids, fatty acids, cardanols, flavan derivatives, triterpenes, prenylated flavanones, anacardic acids, aromatic acids, and their esters, and chalcones, [6,16]. Additionally, due to its complex chemical composition, it has been shown that propolis possesses antimicrobial [17,18], antioxidant [19,20,21], anti-inflammatory [22,23], and antifungal properties [24]. The bioactivity of propolis has been implicated in its flavonoid, phenolic, diterpenic acid, and aromatic acid contents [25]. Globally, propolis formulations are effective antibacterial agents [26,27,28]. Propolis is effective against a wide range of bacterial strains, though it is most effective against Gram-positive bacteria and less effective against Gram-negative bacteria [4,29]. The findings of numerous studies have revealed that the antibacterial action is based on obstruction of bacterial movement and the activity of various bacterial enzymes, as well as a weakening of the cytoplasmic membrane [29]. Propolis from several countries, including Spain, Romania, and China, was found to contain fructose, glucose, galactose, stachyose, and sucrose [30]. Propolis contains essential amino acids, such as proline and arginine, which are needed for cell regeneration and can vary depending on the flora and environment around bee colonies [31]. Terpenoids are the volatile components of propolis that are responsible for the odor or scent that propolis emits. It also significantly contributes to propolis essential oil extract’s biological effects, such as antibacterial and anti-inflammatory properties [32]. According to Sturm and Ulrih (2020), terpenoids were isolated in propolis for the first time in 2011, and 133 terpenes have been reported in propolis so far. Only 16 alkaloids have been isolated from Brazil and Algeria to date [33]. Hexadecanoic acid, methyl ester, is a fatty acid with antioxidant, hepatoprotective, anticancer, anti-inflammatory, anticoronary, anti-arthritic, antieczemic, antihistaminic, and antiandrogenic properties [34].
Therefore, the current study aims to evaluate the antibacterial activities, physicochemical characterization, phytochemical screening, and gas chromatography–mass spectrometry (GC-MS) analysis of various propolis extracts from the chosen area.
2. Materials and Methods
2.1. Chemicals and Apparatus
All of the chemicals and reagents used were of analytical grade purity. Methanol, ethanol, nutrient agar, Mueller–Hinton agar (MHA), and dimethyl sulfoxide (DMSO) were purchased from Himedia (Mumbai, India). Other chemicals used in this experiment were of the highest quality and commercially available on the market. Streptomycin was also procured from Himedia (Mumbai, India). Throughout the media preparations and measurements, ultrapure water was used.
2.2. Collection of Propolis Sample
Crude propolis samples produced by Ceranaindica bees were obtained from honeybee colonies in Chunt-Waliwar, Ganderbal, Jammu, and Kashmir, India (Figure 1a,b). By scraping the surfaces of the walls, frames, entrances, and coverings, propolis was recovered from the beehive [35]. Prior to analysis, the propolis sample was stored at −20 °C.
Figure 1.
(a) The image of map showing the location from where the C. indica propolis was collected. (b) The image of crude propolis sample produced by C. indica honeybees.
2.3. Extraction Procedure
2.3.1. Ethanolic Extract (EEKP)
The 30 g of powdered propolis was extracted using a maceration process with 100 mL of ethanol for at least 3 days. The extract was filtered by using Whatman No.1 filter paper. The extract was dried under pressure using a rotatory evaporator and kept at −20 °C prior to further analysis.
2.3.2. Methanolic Extract (MEKP)
The 30 g of powdered propolis was extracted using a maceration process with 100 mL of methanol for at least 3 days. The extract was filtered using Whatman No. 1 filter paper. The extract was dried under pressure using a rotatory evaporator and kept at −20 °C prior to further analysis.
2.3.3. Aqueous Extract (AqEKP)
About 30 g of Propolis was chopped into pieces and extracted with 100 mL of distilled water. The samples were heated for 5 min on a hot plate with constant agitation at 60 °C before being left at room temperature for a night before being filtered. The resulting mixture was filtered through Whatman filter paper No.1 and concentrated at low temperatures using the freeze-drying method. The extracted samples were kept at −20 °C before the analysis.
2.4. Qualitative Phytochemical Analysis
The different extracts of propolis were subjected to qualitative analysis to identify its constituents, including alkaloids, saponins, tannins, flavonoids, terpenoids, phlobatanins, proteins, and carbohydrates, by following standard protocols [36,37,38,39].
2.5. Identification and Quantification of Bioactive Compounds Using GC-MS
GC-MS analysis was performed by using GC-MS/MS-7000D Agilent (Agilent technologies, Santa Clara, CA, USA), equipped with Agilent J&W, GC-MS column HP-5Ms (15 m × 250 mm × 0.25 µm). The carrier gas was helium at a flow rate of 1 mL/min, and the injector temperature was 280 °C in split-less mode. The oven temperature was initially held at 60 °C for 4 min before being increased to 150 °C at a rate of 10 °C/min for 15 min. The following parameters were used to optimize the mass spectra: the source temperature is 280 °C, and the transfer temperature is 150 °C. The solvent delay time was 2 min, and the scan range was 35–500 Da. The temperature was finally raised to 310 °C. The GC’s total run time was 40.5 min. By comparing their mass spectra to data from the National Institute of Standards and Technology (NIST) library, the compounds were identified.
2.6. Antibacterial Screening
The agar well diffusion method was used to assess the antibacterial activity of various propolis extracts [40]. After being sterilized at 121 °C for 25 min, all the selected bacterial colonies were first sub-cultured in Nutrient Agar Media 2 (NAM) with a pH of 7. About 4 mL of the NAM was added to test tubes to produce the agar slants, which were then incubated at 37 °C overnight. Tubes containing 15 mL of MHA were inoculated with freshly prepared bacterial inoculums using a sterile loop to ensure uniform distribution of inoculums. The pre-inoculated medium was poured into Petri plates and allowed to solidify before cutting 8 mm wells with a sterile cork borer. The wells were filled with 100 µL of extract at various concentrations (100, 200, and 400 µg mL−1) and an equivalent volume of DMSO, which served as a negative control. After standing for 30 min to allow for pre-diffusion of the extract into the medium, the plates were incubated at 37 °C for 16–20 h. The inhibition zones on the plates were ascertained, and the findings were compared to the positive control containing streptomycin (10 µg mL−1). All assays were carried out in triplicate, and mean values were obtained.
2.7. Bacterial Strains
The five bacterial strains used in this study, viz. Pseudomonas aeruginosa (MTCC1688), Escherichia coli (MTCC443), Klebsiella pneumoniae (MTCC19), Cutibacterium acnes (MTCC843), and Staphylococcus aureus (MTCC96) were obtained from the Institute of Microbial Technology (IMTECH), Chandigarh, India. As a positive control, streptomycin (10 µg mL−1) was used.
3. Results
3.1. Phytochemical Analysis
The propolis extracts were phytochemically analyzed and found to contain bioactive components, such as terpenoids, flavonoids, alkaloids, phenols, tannins, and saponins. The efficacy of the three solvents in extracting various components of propolis is compared in Table 1.
Table 1.
Phytochemical screening of propolis extracts.
3.2. GC-MS Analysis
Since EEKP produced the maximum number of phytochemicals when compared to MEKP and AqEKP, GC-MS analysis was performed to determine EEKP’s chemical profile. The GC-MS chromatogram of C. indica propolis extract shown in Figure 2 shows a total of 68 peaks corresponding to bioactive compounds identified by comparing their mass spectral fragmentation patterns to those of known compounds described in the NIST library. The chemical constituents identified in Table 2 are listed by retention time, peak area (%), and molecular weight. The most common phyto-constituents found in propolis extract are alpha-D-Mannopyranoside, methyl, cyclic 2,3:4,6-bis-ethyl boronate (21.17%), hexadecanoic acid, methyl ester (9.91%), nona-2,3-dienoic acid, ethyl ester (4.75%), bacteriochlorophyll-c-stearyl (4.41%), 10-methyldodecan-4-olide (3.89%), and nickel, cyclopentadienyl-1,2,3-trimethylallyl (3.12%).
Figure 2.
Gas chromatography–mass spectrometry (GC-MS) chromatogram of significant propolis compounds.
Table 2.
GC-MS analysis used to identify bioactive compounds in propolis extract (mean ± SD, n = 3.0).
3.3. Antibacterial Activity
Table 3 and Figure 3 show the antibacterial properties of different extracts of Kashmiri propolis. EEKP, MEKP, and AqEKP had nearly identical antimicrobial activities. Small differences were observed in the majority of cases (1–3 mm). Only in the cases of E. coli and C. acnes did MEKP and AqEKP show no activity at 100 µg mL−1.
Table 3.
Antimicrobial capacity of various extracts of propolis against tested bacterial strains using agar well diffusion method.
Figure 3.
The zone of inhibition (mm) of different extracts of C. indica propolis against the selected bacterial strains. (A) EEKP vs. P. aeruginosa. (B) EEKP vs. S. aureus. (C) EEKP vs. K. pneumoniae. (D) MEKP vs. K. pneumoniae. (E) MEKP vs. P. aeruginosa. (F) AqEKP vs. S. aureus. EEKP: ethanolic extract of Kashmiri propolis; MEKP: methanolic extract of Kashmiri propolis; AqEKP: Aqueous extract of Kashmiri propolis.
4. Discussion
The propolis extracts used in the current study showed the existence of a range of bioactive components, including carbohydrates, aldehydes, flavonoids, alkaloids, terpenoids, alcohols, cardiac glycosides, tannins, coumarins, amino acids, phytobatanins, saponins, etc. These phytochemicals could be responsible for the pharmacological properties of the propolis extracts. Propolis is commercialized globally and is considered a significant source of phytochemicals that have pharmacological effects [41]. The presence of 68 compounds from various groups was revealed by the GC-MS analysis, including flavonoids, flavonoid derivatives, terpenes, aromatic acids, and their related esters.
The extracts of propolis have a strong effect against bacteria, such as Enterococcus spp., Escherichia coli, and Staphylococcus aureus [42,43]. In the present studies, the antibacterial activity of various extracts of propolis was tested against an array of bacterial strains. The EEKP was found to possess comparatively stronger antimicrobial activity than MEKP and AqEKP. The highest microbial activity in the EEKP may be due to the highest concentration of flavonoid and phenolic compounds, which may inhibit microorganisms [44]. Another factor is that the majority of naturally occurring secondary metabolites are highly soluble in organic solvents; as a result, the ethanolic extract has the highest microbial activity, followed by MEKP and AqEKP [45]. The propolis extracts had significant antibacterial activity against Staphylococcus aureus but no activity against E. coli, according to studies from China and Canada [46,47]. The propolis ethanolic extracts have shown the highest levels of antimicrobial activity against a variety of microorganisms in Brazil [48]. In Vietnam, propolis crude extract demonstrated significant antibacterial activity against S. aureus and inhibited E. coli at lower doses [49]. This is because propolis contains flavones and flavonols that have been isolated from it [50], as well as large levels of terphenyl esters and hydroxybenzoic acid, both of which have antibacterial and antifungal properties [51]. Components of propolis, such as Pinocembrin, exhibit antibacterial action against Streptococcus species, whereas p-Coumaric acid, artepillin,3-phenyl-4-di hydrocinnamylocinnamic acid inhibits H. pylori, and Apigenin substantially inhibits bacterial glycosyltransferase [52].
5. Conclusions
The present work is the first approach to identify numerous bioactive components by GC-MS analysis and to assess the antibacterial potency of various extracts of C. indica propolis from the Kashmir region. The GC-MS analysis of propolis has revealed the presence of 68 bioactive compounds that have a wide range of pharmacological potential, including antibacterial, antifungal, anti-protozoal, antioxidant, hepatoprotective, anti-inflammatory, anticancer, and so on. The presence of these bioactive compounds in propolis is responsible for various therapeutic and pharmacologic properties in traditional medicine. More research is needed to isolate a specific substance that results in a positive result in a biological assay, and appropriate methodologies for in-depth studies should be developed.
Author Contributions
Conceptualization, I.M. and F.S.; methodology, I.M., T.R.K., M.I.Z. and P.A.; software, S.A. and F.S.; validation, S.U.D.W., F.S., S.A. and W.A.M.; formal analysis, S.U.D.W.; investigation, T.R.K. and M.I.Z.; resources, W.A.M. and S.A.; data curation, P.A.; writing—original draft preparation, I.M.; writing—review and editing, F.S., S.A. and W.A.M.; visualization, W.A.M.; supervision, I.M.; project administration, I.M.; funding acquisition, W.A.M. All authors have read and agreed to the published version of the manuscript.
Funding
This research project was supported by Researchers Supporting Project number (RSP2022R516), King Saud University, Riyadh, Saudi Arabia, and APC was supported by the RSP.
Institutional Review Board Statement
Not applicable.
Informed Consent Statement
Not applicable.
Data Availability Statement
Not applicable.
Acknowledgments
Authors are thankful to the Researchers Supporting Project number (RSP2022R516), King Saud University, Riyadh, Saudi Arabia, for supporting this work.
Conflicts of Interest
The authors declare no conflict of interest.
References
- Park, Y.K.; Alencar, S.M.; Aguiar, C.L. Botanical origin and chemical composition of Brazilian propolis. J. Agric. Food Chem. 2002, 50, 2502–2506. [Google Scholar] [CrossRef] [PubMed]
- Tosic, S.; Stojanovic, G.; Mitic, S.; Pavlovic, A.; Alagic, S. Mineral composition of selected Serbian propolis samples. J. Apic. Sci. 2017, 61, 5–15. [Google Scholar] [CrossRef]
- Al-Ani, I.; Zimmermann, S.; Reichling, J.; Wink, M. Antimicrobial activities of European propolis collected from various geographic origins alone and in combination with antibiotics. Medicines 2018, 5, 2. [Google Scholar] [CrossRef]
- Silva-Carvalho, R.; Baltazar, F.; Almeida-Aguiar, C. Propolis: A complex natural product with a plethora of biological activities that can be explored for drug development. Evid. Based Complement. Altern. Med. 2015, 2015, 206439. [Google Scholar] [CrossRef] [PubMed]
- Papachroni, D.; Graikou, K.; Kosalec, I.; Damianakos, H.; Ingram, V.; Chinou, I. Phytochemical analysis and biological evaluation of selected African propolis samples from Cameroon and Congo. Nat. Prod. Commun. 2015, 10, 6–70. [Google Scholar] [CrossRef]
- Farooqui, T.; Farooqui, A.A. Beneficial effects of propolis on human health and neurological diseases. Front. Biosci. 2012, 4, 779–793. [Google Scholar] [CrossRef]
- Nilesh, K.; Mueen, A.K.; Raman, D.; Ahmed, H. Antioxidant and antimicrobial activity of propolis from Tamilnadu zone. J. Med. Plant Res. 2008, 2, 361–364. [Google Scholar]
- Parolia, A.; Thomas, M.S.; Kundabala, M.; Mohan, M. Propolis and its potential uses in oral health. Int. J. Med. Med. Sci. 2010, 2, 210–215. [Google Scholar]
- Marcucci, M.C.; Rodriguez, J.; Ferreres, F.; Bankova, V.; Groto, R.; Popov, S. Chemical composition of Brazilian propolis from São Paulo state. Z. Naturforsch. C 1998, 53, 117–119. [Google Scholar] [CrossRef]
- Bankova, V.S.; De Castro, S.L.; Marcucci, M.C. Propolis: Recent advances in chemistry and plant origin. Apidologie 2000, 31, 3–15. [Google Scholar] [CrossRef]
- Akbay, E.; Özenirler, Ç.; Çelemli, Ö.G.; Durukan, A.B.; Onur, M.A.; Sorkun, K. Effects of propolis on warfarin efficacy. Pol. J. Thor. Cardiovas. Surg. 2017, 14, 43–46. [Google Scholar] [CrossRef]
- Kakino, M.; Izuta, H.; Tsuruma, K.; Araki, Y.; Shimazawa, M.; Ichihara, K.; Hara, H. Laxative effects and mechanism of action of Brazilian green propolis. BMC Complement. Altern. Med. 2012, 12, 192. [Google Scholar] [CrossRef]
- De Figueiredo, S.M.; Binda, N.S.; Almeida, B.D.M.; Abreu, S.R.L.; De Abreu, J.A.S.; Pastore, G.M.; Sato, H.H.; Toreti, V.C.; Tapia, A.V.; Park, Y.K.; et al. Green propolis: Thirteen constituents of polar extract and total flavonoids evaluated during six years through RP-HPLC. Curr. Drug Discov. Technol. 2015, 12, 229–239. [Google Scholar] [CrossRef]
- Biluca, F.C.; Braghini, F.; Gonzaga, L.V.; Costa, A.C.O.; Fett, R. Physicochemical profiles, minerals and bioactive compounds of stingless bee honey (Meliponinae). J. Food Compost. Anal. 2016, 50, 61–69. [Google Scholar] [CrossRef]
- Lim, D.C.C.; Bakar, M.A.; Majid, M. Nutritional composition of stingless bee honey from different botanical origins. IOP Conf. Ser. Earth Environ Sci. 2019, 269, 012025. [Google Scholar] [CrossRef]
- Popova, M.; Dimitrova, R.; Al-Lawati, H.T.; Tsvetkova, I.; Najdenski, H.; Bankova, V. Omani propolis: Chemical profiling, antibacterial activity and new propolis plant sources. Chem. Cent. J. 2013, 7, 158. [Google Scholar] [CrossRef][Green Version]
- Velikova, M.; Bankova, V.; Tsvetkova, I.; Kujumgiev, A.; Marcucci, M.C. Antibacterial ent-kaurene from Brazilian propolis of native stingless bees. Fitoterapia 2000, 71, 693–696. [Google Scholar] [CrossRef]
- Barrientos, L.; Herrera, C.L.; Montenegro, G.; Ortega, X.; Veloz, J.; Alvear, M.; Cuevas, A.; Saavedra, N.; Salazar, L.A. Chemical and botanical characterization of Chilean propolis and biological activity on cariogenic bacteria Streptococcus mutans and Streptococcus sobrinus. Braz. J. Microbiol. 2013, 44, 577–585. [Google Scholar] [CrossRef]
- Sawaya, A.C.H.F.; Calado, J.C.P.; Santos, L.D.; Marcucci, M.C.; Akatsu, I.P.; Soares, A.E.E.; Abdelnur, P.V.; Cunha, I.B.D.S.; Eberlin, M.N. Composition and antioxidant activity of propolis from three species of Scaptotrigona stingless bees. J. ApiProd. ApiMed. Sci. 2009, 1, 37–42. [Google Scholar] [CrossRef]
- Guimarães, N.S.; Mello, J.C.; Paiva, J.S.; Bueno, P.C.; Berretta, A.A.; Torquato, R.J.; Nantes, I.L.; Rodrigues, T. Baccharisdracunculifolia, the main source of green propolis, exhibits potent antioxidant activity and prevents oxidative mitochondrial damage. Food Chem. Toxicol. 2012, 50, 1091–1097. [Google Scholar] [CrossRef]
- Campos, J.F.; Dos Santos, U.P.; Macorini, L.F.B.; De Melo, A.M.M.F.; Balestieri, J.B.P.; Paredes-Gamero, E.J.; Cardoso, C.A.L.; Souza, K.D.P.; Dos Santos, E.L. Antimicrobial, antioxidant and cytotoxic activities of propolis from Meliponaorbignyi (Hymenoptera, Apidae). Food Chem. Toxicol. 2014, 65, 374–380. [Google Scholar] [CrossRef] [PubMed]
- Barbarić, M.; Mišković, K.; Bojić, M.; Lončar, M.B.; Smolčić-Bubalo, A.; Debeljak, Ž.; Medić-Šarić, M. Chemical composition of the ethanolicpropolis extracts and its effect on HeLa cells. J. Ethnopharmacol. 2011, 135, 772–778. [Google Scholar] [CrossRef]
- Cavendish, R.L.; De Souza Santos, J.; Neto, R.B.; Paixão, A.O.; Oliveira, J.V.; De Araujo, E.D.; Silva, A.E.B.E.; Thomazzi, S.M.; Cardoso, J.C.; Gomes, M.Z. Antinociceptive and anti-inflammatory effects of Brazilian red propolis extract and formononetin in rodents. J. Ethnopharmacol. 2015, 173, 127–133. [Google Scholar] [CrossRef]
- Viuda-Martos, M.; Ruiz-Navajas, Y.; Fernández-López, J.; Pérez-Álvarez, J.A. Functional properties of honey, propolis, and royal jelly. J. Food Sci. 2008, 73, 117–124. [Google Scholar] [CrossRef] [PubMed]
- Coneac, G.; Gafiţanu, E.; Hădărugă, D.I.; Hădărugă, N.G.; Pînzaru, I.A.; Bandur, G.; Ursica, L.; Paunescu, V.; Gruia, A. Flavonoid contents of propolis from the west side of Romania and correlation with the antioxidant activity. Chem. Bull. Politeh. Univ. 2008, 53, 56–60. [Google Scholar]
- Da SilveiraRegueira-Neto, M.; Tintino, S.R.; Da Silva, A.R.P.; Costa, M.D.S.; Oliveira-Tintino, C.D.D.M.; Boligon, A.A.; Menezes, I.R.A.; Balbino, V.D.Q.; Coitinho, D.D.M. Comparative analysis of the antibacterial activity and HPLC phytochemical screening of the Brazilian red Propolis and the resin of Dalbergiaecastaphyllum. Chem. Biodivers. 2019, 16, 1900344. [Google Scholar]
- Bogdanov, S. Propolis: Biological properties and medical applications. In The Propolis Book; Chapter 2; Publisher Bee Product Science: Bern, Switzerland, 2017; pp. 1–41. Available online: https://www.researchgate.net/publication/304012147_Propolis_biological_properties_and_medical_applications (accessed on 8 September 2022).
- Isidorov, V.A.; Szczepaniak, L.; Bakier, S. Rapid GC/MS determination of botanical precursors of Eurasian propolis. Food Chem. 2014, 142, 101–106. [Google Scholar] [CrossRef]
- Mirzoeva, O.K.; Grishanin, R.N.; Calder, P.C. Antimicrobial action of propolis and some of its components: The effects on growth, membrane potential and motility of bacteria. Microbiol. Res. 1997, 152, 239–246. [Google Scholar] [CrossRef]
- Qian, W.L.; Khan, Z.; Watson, D.G.; Fearnley, J. Analysis of sugars in bee pollen and propolis by ligand exchange chromatography in combination with pulsed amperometric detection and mass spectrometry. J. Food Compost. Anal. 2008, 21, 78–83. [Google Scholar] [CrossRef]
- Mulyati, A.H.; Sulaeman, A.; Marliyati, S.A.; Rafi, M.; Fikri, A.M. Phytochemical analysis and antioxidant activities of ethanol extract of stingless bee propolis from Indonesia. AIP Conf. Proc. 2020, 2243, 30014. [Google Scholar]
- Bankova, V.; Popova, M.; Trusheva, B. Propolis volatile compounds: Chemical diversity and biological activity: A review. Chem. Cent. J. 2014, 8, 28. [Google Scholar] [CrossRef]
- Šturm, L.; Ulrih, N.P. Advances in the propolis chemical composition between 2013 and 2018: A review. eFood 2020, 1, 24–37. [Google Scholar] [CrossRef]
- Krishnamoorthy, K.; Subramaniam, P. Phytochemical profiling of leaf, stem, and tuber parts of Solenaamplexicaulis (Lam.) Gandhi using GC-MS. Int. Sch. Res. Not. 2014, 2014, 567409. [Google Scholar]
- Marletto, F. Propolis Characteristics in Relation to the Floral Origin and the Bees’ Utilization of It; Apicoltore Moderno: Turin, Italy, 1983; pp. 187–191. [Google Scholar]
- Harborne, A.J. Phytochemical Methods a Guide to Modern Techniques of Plant Analysis, 3rd ed.; Chapman & Hall: London, UK, 1998; Volume XIV, 302p. [Google Scholar]
- Misra, C.S.; Pratyush, K.; Sagadevan, L.D.M.; James, J.; Veettil, A.K.T.; Thankamani, V. A comparative study on phytochemical screening and antibacterial activity of roots of Alstoniascholaris with the roots, leaves and stem bark. Int. J. Pharm. Pharm. Res. 2011, 1, 77–82. [Google Scholar]
- Vijayalakshmi, R.; Ravindhran, R. Preliminary comparative phytochemical screening of root extracts of Diospyrusferrea (Wild.) Bakh and Aervalanata (L.) Juss. Ex Schultes. Asian J. Plant Sci. Res. 2011, 2, 581–587. [Google Scholar]
- Gul, R.; Jan, S.U.; Faridullah, S.; Sherani, S.; Jahan, N. Preliminary phytochemical screening, quantitative analysis of alkaloids, and antioxidant activity of crude plant extracts from Ephedra intermedia indigenous to Balochistan. Sci. World J. 2017, 2017, 5873648. [Google Scholar] [CrossRef]
- Dhilna, C.R.; Gopinath, S.M.; Sajith, A.M.; Savitha, B.; Shruthi, S.D.; Joy, M.N. Some imidazolylbenzamides as potent antibacterial agents. AIP Conf. Proc. 2020, 2280, 030004. [Google Scholar]
- Miyataka, H.; Nishiki, M.; Matsumoto, H.; Fujimoto, T.; Matsuka, M.; Satoh, T. Evaluation of propolis. I. Evaluation of Brazilian and Chinese propolis by enzymatic and physico-chemical methods. Biol. Pharm. Bull. 1997, 20, 496–501. [Google Scholar] [CrossRef]
- Noori, A.L.; Al-Ghamdi, A.; Ansari, M.J.; Al-Attal, Y.; Salom, K. Synergistic effects of honey and propolis toward drug multi-resistant Staphylococcus aureus, Escherichia coli and Candida albicans isolates in single and polymicrobial cultures. Int. J. Med. Sci. 2012, 9, 793. [Google Scholar]
- Kasiotis, K.M.; Anastasiadou, P.; Papadopoulos, A.; Machera, K. Revisiting Greek propolis: Chromatographic analysis and antioxidant activity study. PLoS ONE 2017, 12, e0170077. [Google Scholar] [CrossRef]
- Mercan, N.; Kivrak, I.; Duru, M.E.; Katircioglu, H.; Gulcan, S.; Malci, S.; Acar, G.; Salih, B. Chemical composition effects onto antimicrobial and antioxidant activities of propolis collected from different regions of Turkey. Ann. Microbiol. 2006, 56, 373–378. [Google Scholar] [CrossRef]
- Gupta, A.; Naraniwal, M.; Kothari, V. Modern extraction methods for preparation of bioactive plant extracts. J. Appl. Nat. Sci. 2012, 1, 8–26. [Google Scholar]
- Ding, Q.; Sheikh, A.R.; Gu, X.; Li, J.; Xia, K.; Sun, N.; Wu, R.A.; Luo, L.; Zhang, Y.; Ma, H. Chinese Propolis: Ultrasound-assisted enhanced ethanolic extraction, volatile components analysis, antioxidant and antibacterial activity comparison. Food Sci. Nutr. 2021, 9, 313–330. [Google Scholar] [CrossRef] [PubMed]
- Allan, R. Antibacterial activity of propolis and honey against Staphylococcus aureus and Escherichia coli. Afr. J. Microbiol. Res. 2010, 4, 1872–1878. [Google Scholar]
- Silva, R.P.D.; Machado, B.A.S.; Barreto, G.D.A.; Costa, S.S.; Andrade, L.N.; Amaral, R.G.; Carvalho, A.A.; Padilha, F.F.; Barbosa, D.D.V.; Umsza-Guez, M.A. Antioxidant, antimicrobial, antiparasitic, and cytotoxic properties of various Brazilian propolis extracts. PLoS ONE 2017, 12, e0172585. [Google Scholar]
- Georgieva, K.; Popova, M.; Dimitrova, L.; Trusheva, B.; Thanh, L.N.; Phuong, D.T.L.; Lien, N.T.P.; Najdemski, H.; Bankova, V. Phytochemical analysis of Vietnamese propolis produced by the stingless bee Lisotrigonacacciae. PLoS ONE 2019, 14, e0216074. [Google Scholar] [CrossRef]
- Jug, M.; Karas, O.; Kosalec, I. The influence of extraction parameters on antimicrobial activity of propolis extracts. Nat. Prod. Commun. 2017, 12, 47–50. [Google Scholar] [CrossRef]
- Popova, M.; Trusheva, B.; Antonova, D.; Cutajar, S.; Mifsud, D.; Farrugia, C.; Tsvetkova, I.; Najdenski, H.; Bankova, V. The specific chemical profile of Mediterranean propolis from Malta. Food Chem. 2011, 126, 1431–1435. [Google Scholar] [CrossRef]
- Martinotti, S.; Ranzato, E. Propolis: A new frontier for wound healing? Burns Trauma 2015, 3, 9. [Google Scholar] [CrossRef]
Publisher’s Note: MDPI stays neutral with regard to jurisdictional claims in published maps and institutional affiliations. |
© 2022 by the authors. Licensee MDPI, Basel, Switzerland. This article is an open access article distributed under the terms and conditions of the Creative Commons Attribution (CC BY) license (https://creativecommons.org/licenses/by/4.0/).